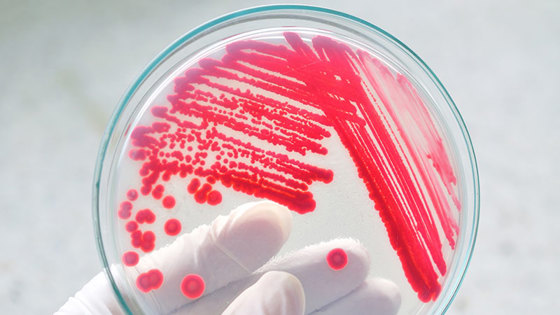

Mindre og riktigere bruk av antibiotika
Historisk arkiv
Publisert under: Regjeringen Solberg
Utgiver: Landbruks- og matdepartementet
Nyhet | Dato: 23.06.2015
De neste fem årene skal Norge redusere bruken av antibiotika med tretti prosent innen 2020. Det foreslår Regjeringen i Nasjonal strategi mot antibiotikaresistens 2015-2020 som legges fram i dag.
Det er en sammenheng mellom human-, dyre- og fiskehelse og miljø når det gjelder utvikling av antibiotikaresistens. Helse- og omsorgsdepartementet, Landbruks- og matdepartementet, Klima- og miljødepartementet og Nærings- og fiskeridepartementet har i dag lagt fram en nasjonal strategi mot antibiotikaresistens 2015-2020.
Hovedmålene i den nye nasjonale strategien mot antibiotikaresistens er at Norge de neste fem årene redusere bruken av antibiotika med tretti prosent, bruke antibiotika riktigere, øke kunnskapen om hva som driver utvikling og spredning av antibiotikaresistens og være en pådriver i internasjonalt med utvikling av nye antibiotika og vaksiner.
Vil redusere bruk av antibiotika i husdyrproduksjonen
Norge er et av landene i verden som bruker desidert minst antibiotika i matproduksjonen (husdyrproduksjonen). Likevel ønsker Regjeringen at Norge skal bli enda bedre, og foreslår at forbruket av antibiotika til matproduserende landdyr skal reduseres med ytterligere 10 prosent sammenlignet med forbruket i 2013.
– Selv om vi er blant de absolutt beste i verden skal vi ikke hvile på laurbærene. Vi skal få forbruket av antibiotika ytterligere ned, sier landbruks- og matminister Sylvi Listhaug.
Skal også redusere antibiotikabruk til kjæledyr
Situasjonen er motsatt for kjæledyrene våre. Vi har hatt en økning i bruken av antibiotika til kjæledyr på 18 prosent fra 2005-2013. Denne utviklingen ønsker regjeringen å snu.
– Regjeringen foreslår å redusere bruken av antibiotika til kjæledyrene våre med 30 prosent. Det er også bekymringsfullt at bruken av de bredspektrede, eller de sterkere antibiotikatypene, har økt mest. Kjæledyr får samme type antibiotika som mennesker, så det er utrolig viktig at vi får ned bruken når vi vet at resistente bakterier kan overføres mellom kjæledyr og mennesker, sier Listhaug.
Regjeringen jobber også internasjonalt for at norske regler som forbud mot å bruke antibiotika som vekstfremmer, og forbud mot at veterinærer skal tjene penger på å selge antibiotika, skal bli spredd til andre land.
Noen av de viktigste tiltakene i strategien er å:
-
Styrke kunnskapsgrunnlaget
-
Øke kunnskapsnivået og kompetansen om bruk av antibiotika i befolkningen og hos forskrivere
-
Optimalisere forskrivningspraksis i alle sektorer
-
Bedre infeksjonskontroll
-
Behandle og sanere infeksjoner med resistente bakterier
-
Styrke normativt, internasjonalt samarbeid
-
Bidra internasjonalt til utviklingen av vaksiner, nye antibiotika og diagnostiske hjelpemidler
